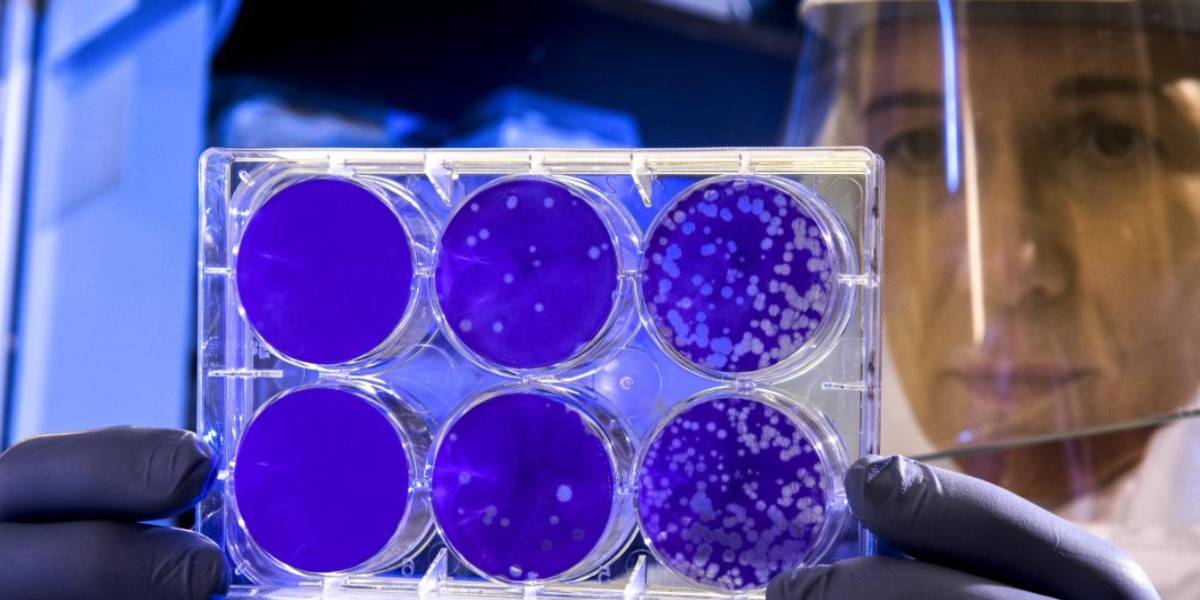
Tercera dosis de Sinovac eleva inmunidad anti-COVID-19, según estudio

Según la investigación, los niveles de inmunidad bajan significativamente tras unos seis meses.
-
 La vacuna de Sinovac se convirtió en junio en la segunda vacuna contra la covid desarrollada en China en recibir la autorización de la OMS.
La vacuna de Sinovac se convirtió en junio en la segunda vacuna contra la covid desarrollada en China en recibir la autorización de la OMS.
Una tercera dosis de la vacuna contra el coronavirus SARS-CoV-2 desarrollada por la farmacéutica china Sinovac eleva los niveles de protección inmune entre tres y cinco veces, según un estudio preliminar del que se hace eco hoy el diario privado hongkonés South China Morning Post.
El estudio fue llevado a cabo por una decena de expertos de universidades e instituciones públicas del país, así como de la propia empresa desarrolladora del antígeno, y publicado en el portal médico MedRxiv, que advierte de que todavía no ha pasado por todas las fases de revisión y que, por tanto, no debe ser tomado todavía como "información verificada".
Según sus hallazgos, los niveles de inmunidad bajan significativamente tras unos seis meses, pero una dosis de refuerzo inoculada entre unos seis y ocho meses tras la segunda inyección genera un "fuerte impulso para la respuesta inmune".
"La media geométrica de los títulos (MGT) de anticuerpos se eleva a aproximadamente 140. Esta subida se corresponde con un aumento de entre 3 y 5 veces en los títulos de anticuerpos neutralizantes (con respecto a los) de 28 días después de (recibir) la segunda dosis", apunta el documento.
El estudio se basa en la experiencia con unos 540 participantes sanos de entre 18 y 59 años que recibieron una tercera dosis en diferentes períodos tras recibir la segunda.
Pese a que sí especifican el período en el que mejor respuesta inmune se registró, los investigadores no proponen directamente un marco temporal para la inyección de una dosis de refuerzo y aseguran que para establecerlo hay que "tener en cuenta muchos factores" como la eficacia de la vacuna, la situación local de la pandemia, los riesgos de infección y los suministros de antígenos.
La vacuna de Sinovac se convirtió en junio en la segunda vacuna contra la covid desarrollada en China en recibir la autorización de la Organización Mundial de la Salud (OMS) para su uso de emergencia.
El suero, llamado CoronaVac, se está empleando en países latinoamericanos como Ecuador, Colombia, Uruguay, México, El Salvador, República Dominicana o Chile.
Recomendadas